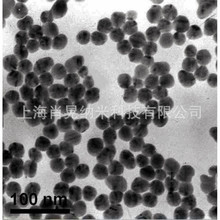
���̼��΢��̼������̼�� �������l�{��̼�� C

共 459件
微米 球
相關產品
所有類目
-
球批發家用廚房含皂微米清潔球用品去污鋼絲球廠家非不銹鋼棉
-
亮樂球批發廚房含皂微米清潔球用品去污鋼絲球非不銹鋼棉去油
-
導電碳粉微米碳粉球形碳粉 零售批發納米碳球 C
-
【地板定制】懸浮廠家幼兒園室外操場跑道拼裝地板羽毛球匹克球
-
懸浮地板微米籃球場塑戶外地板操場益智地板生產各種防滑專用懸浮
-
opp果丹皮包裝膜定制透明單張玻璃紙山楂卷手工包食品塑料包裝膜 厚度 18-40微米
-
類球單晶微米金剛石粉鑽石粉精細拋光用2um
-
微米銅珠焊接9.525mm實心銅球拋光鏡面光滑光亮金屬球亮飾
-
球形鈮粉等離子球化低氧鈮粉激光熔覆3D打印噴塗鈮粉超細微米鈮粉
-
球形鈮粉等離子球化低氧鈮粉激光熔覆3D打印噴塗鈮粉超細微米鈮粉
-
環氧基有機硅微米球水分散體 表面消光效果啞光質感 絲爽手感7013
-
高純塗層氮化鈦粉末納米陶瓷球 TiN 立方超細微米科研實驗氮化鈦
-
慢回彈深睡枕梵詩亞朵記憶棉枕頭護頸椎助睡眠成人女生家用球枕芯
-
99.7%球形鎳粉 球化 高純鎳粉45-15?m微米級霧化鎳粉末
-
馬爾文微米校准標液 3微米乳膠球粒子 (不含COA證書) 型號:LTX420
-
球形狀尺寸探測誤差(PF Ps)啞光陶瓷球AUBAT-MATT10奧本精密微米
-
德國工程背景DVK 有機硅微米球2446
-
微米球形氧化鈰 納米二氧化鈰 超細高純稀土CeO2 類球
-
亮樂球批發廚房含皂微米清潔球用品去污鋼絲球廠家非不銹鋼棉家居
-
高純塗層氮化鈦粉末納米陶瓷球 TiN 立方超細微米科研實驗氮化鈦
-
6205滾珠軸承適用於微米級超精密應用
-
軸承座組件 帶座軸承 圓法蘭襯套型軸承座軸支座BARB軸承固定座 null 軸承內徑3-623ZZ-L20、軸承內徑4-624ZZ-L20、軸承內徑5-605ZZ-L20、軸承內徑5-625ZZ-L25、軸承內徑6-606ZZ-L20、軸承內徑6-626ZZ-L25、軸承內徑8-698ZZ-L25、軸承內徑8-608ZZ-L25、軸承內徑8-628ZZ-L25、軸承內徑10-6800ZZ-L20、軸承內徑10-6900ZZ-L25、軸承內徑10-6000ZZ-L25、軸承內徑10-6200ZZ-L30、軸承內徑12-6801ZZ-L25、軸承內徑12-6901ZZ-L25、軸承內徑12-6001ZZ-L25、軸承內徑12-6201ZZ-L30、軸承內徑15-6802ZZ-L25、軸承內徑15-6902ZZ-L25、軸承內徑15-6002ZZ-L30、軸承內徑15-6202ZZ-L35、軸承內徑17-6903ZZ-L30、軸承內徑17-6003ZZ-L35、軸承內徑17-6203ZZ-L40、軸承內徑20-6804ZZ-L35、軸承內徑20-6904ZZ-L35、軸承內徑20-6004ZZ-L40、軸承內徑20-6204ZZ-L45、軸承內徑25-6805ZZ-L35、軸承內徑25-6905ZZ-L35、軸承內徑25-6005ZZ-L40、軸承內徑25-6205ZZ-L45、軸承內徑30-6806ZZ-L35、軸承內徑30-6906ZZ-L35、軸承內徑30-6006ZZ-L40、軸承內徑30-6206ZZ-L50、軸承內徑35-6007ZZ-L50、軸承內徑35-6207ZZ-L60、軸承內徑40-6008ZZ-L60、軸承內徑40-6208ZZ-L60、軸承內徑50-6010ZZ-L70、軸承內徑50-6210ZZ-L90、深溝球軸承608ZZ
-
氧化鋁粉樹脂塗料拋光電子級陶瓷用耐磨煅燒三氧化二鋁高純納米 包裝規格 DCA-500N(500納米),1kg、DCA-01WH(12500目/1微米)1kg、DCA-01W(12500目/1微米)1kg、DCA-02W(6250目/2微米)1kg、DCA-03W(4500目/3微米)1kg、DCA-05W(2500目/5微米)1kg、DCA-10W(1250目/10微米)1kg、DCA-40W(400目/40微米)1kg、DCA-45W(325目/45微米)1kg、DCA-60W(240目/60微米)1kg、DCA-500N,(500納米)改性1kg、DCA-01WH(12500目/1微米),改性1kg、DCA-01W(12500目/1微米),改性1kg、DCA-02W,6250目/2微米)改性1kg、DCA-03W,(4500目/3微米改性1kg、DCA-05W,(2500目/5微米)改性1kg、DCA-10W,(1250目/10微米)改性1kg、DCA-300NSD,(球形300納米)改性1kg、DCA-500NL(類球500納米)改性1kg、DCA-800NL(類球800納米)改性1kg、DCA-300NSD(球形300納米)1kg、DCA-500NL(類球500納米)1kg、DCA-800NL(類球800納米)1kg、DCA-01W,(12500目/1微米),20KG/包、DCA-01WH,(12500目/1微米),20KG/包、DCA-02W(6250目/2微米)20KG/包、DCA-03W(4500目/3微米)20KG/包、DCA-05W(2500目/5微米)25KG/包、DCA-10W(1250目/10微米)25KG/包、DCA-40W(400目/40微米)25KG/包、DCA-45W(325目/45微米)25KG/包、DCA-60W(240目/60微米)25KG/包
-
激光粒度分析儀干法濕法適用碳酸鈣陶瓷粉石墨水泥土壤微球粒徑
-
微縮食玩diy材料仿真巧克力面包樹脂配件迷你奶油膠配件混款食玩 品牌 微米
-
PCL微球 聚己內酯微球原料粉末 20-50微米 實心 生物降解材料 pcl
-
0.1-1000微米納米級PMMA粉末聚甲基丙烯酸甲酯粉 亞克力微球
-
3微米 5微米 8微米 16微米 30微米 40微米 50微米 微球 PS微球
-
空心玻璃微珠保溫隔熱塗料橡膠塑料改性降比重中空玻璃微球微米級
-
玻璃微珠空心保溫隔熱塗料標線反光玻璃珠中空玻璃微球微米級噴砂
-
微米級單分散pmma水晶粉 PMMA微球,聚甲基丙烯酸甲微球PMMA微球
-
空心玻璃微珠保溫隔熱塗料復合材料鞋材減重膠粘劑密封膠中空微球
-
歐百娜匹克球地膠室內定 制PVC地墊 室外懸浮拼裝地板 丙烯酸卷材
-
亞克力100-2000目粉 PMMA微球粉末 微球狀PMMA粉 亞克力樹脂粉
-
廠家原色藤球 鸚鵡啃咬玩具球開發智力磨牙解悶藤球批發
-
15*15cm大紅金銀彩色包裝錫紙 細格橘紋光面糯米蛋紅蛋浴鹽球鋁箔
-
凈水機花灑用鹼性托瑪琳礦化球電氣石濾料活化球 托瑪琳陶瓷球
-
現貨批發高透光燈罩用有機硅光擴散劑 提升爽滑用有機硅微球
-
過濾花灑噴頭熱水器除氯凈水器旅行便攜增壓淋浴頭出水免打孔柔和 規格 (水晶白)除氯美膚花灑【國內國外通用】、(水晶白)除氯美膚花灑【送原裝濾芯*2+除氯盒*2】、(水晶白)除氯美膚花灑+1.5米管【送原裝濾芯*3+除氯盒*3】、(水晶白)除氯美膚花灑+1.5米管+支架【送原裝濾芯*3+除氯盒*3】、(透明灰)除氯美膚花灑【國內國外通用】、(透明灰)除氯美膚花灑【送原裝濾芯*2+除氯盒*2】、(透明灰)除氯美膚花灑+1.5米管【送原裝濾芯*3+除氯盒*3】、(透明灰)除氯美膚花灑+1.5米管+支架【送原裝濾芯*3+除氯盒*3】、多層除氯凈水【5微米PPC-過濾芯-10個裝】、升級原裝【亞硫酸鈣球-除氯盒*10】
-
足浴球包裝錫紙/鋁箔紙 :包裝爆炸鹽 泡腳丸 沐浴丸佛跳牆 彩色紙